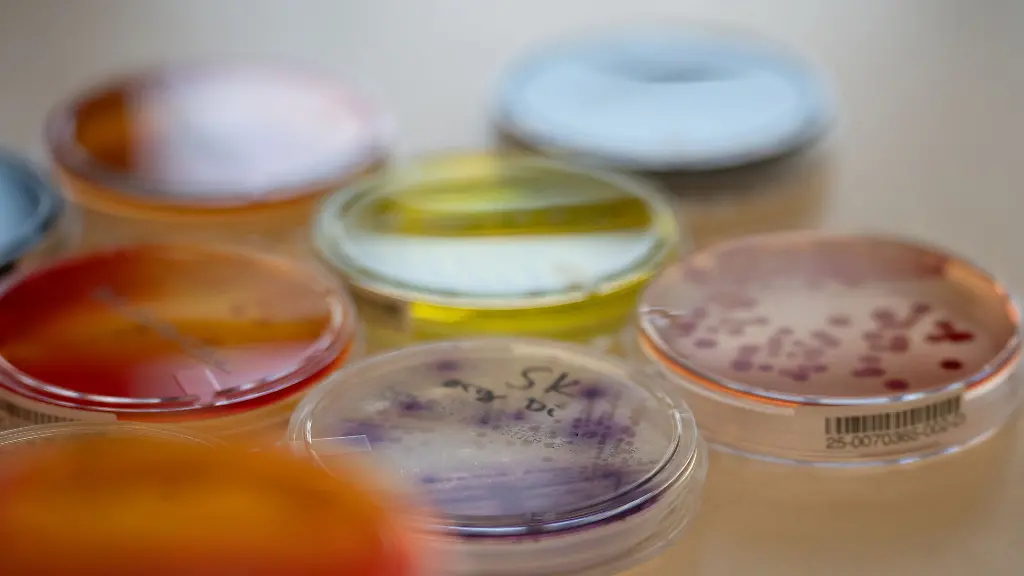

Rheinland-Pfalz & SaarlandAmt: Kaum gesundheitsschädliche Lebensmittel
Salmonellen, Metalle, Chemikalien: Das Landesuntersuchungsamt prüft die Lebensmittel in Rheinland-Pfalz. Im vergangenen Jahr gab es wenige Beanstandungen – doch einzelne Gefahren schon.
Koblenz (dpa/lrs) - Das Landesuntersuchungsamt hat im vergangenen Jahr in Rheinland-Pfalz kaum gesundheitsschädliche Inhalte in untersuchten Lebensmitteln gefunden. Von insgesamt rund 19.400 Stichproben seien nur 13 gesundheitsschädliche Proben identifiziert worden, teilte das Amt in Koblenz mit. 2023 waren es noch 26 gewesen. "Diese Quote ist mit etwa 0,1 Prozent aller untersuchten Proben seit Jahren konstant niedrig", sagte der Präsident Markus Böhl.
Die sogenannte Beanstandungsquote habe insgesamt bei 10,2 Prozent und damit auf dem Niveau der Vorjahre gelegen. Die überwiegende Mehrzahl der Beanstandungen habe eine falsche oder irreführende Kennzeichnung betroffen.
Was genau wurde beanstandet?
In neun Proben wurden laut Mitteilung im vergangenen Jahr bakterielle Verunreinigungen mit krank machenden Bakterien gefunden. Fremdkörpern in Lebensmitteln wurden demnach viermal beanstandet.
"Sprossen, Tahin (Sesampaste) und eine Blattsalatmischung waren mit Salmonellen belastet", hieß es.
In zwei Wurstproben seien E.coli Bakterien, in einer Suppenprobe Bacillus cereus gewesen.
Drei Proben Thunfisch überschritten den Grenzwert von 200 Milligramm pro Kilogramm Histamin um ein Vielfaches.
In geriebenem Käse wurden dünne Metalldrähte gefunden.
In einem Cheeseburger stellte das Amt "zahlreiche harte und spitze Fremdkörper" fest.
Und in einem Erdbeerfruchtaufstrich und einem Elisenlebkuchen wurde jeweils ein scharfkantiger Fremdkörper gefunden.
Den Keimen sei gemeinsam, dass sie selbst oder die von ihnen gebildeten Toxine Erbrechen und schwere Durchfallerkrankungen auslösen können, teilte das Amt mit. "Größere Mengen an Histamin können insbesondere bei sensiblen Personen zu Vergiftungssymptomen wie Atemnot, Blutdruckabfall, Erbrechen, Durchfall und Hautrötungen führen", hieß es.